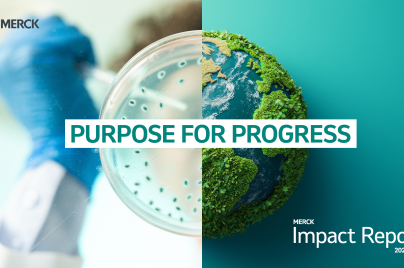
image of half of a petri dish and half of an earth merged to make a full circle. Text on top says "Purpose for Progress Impact Report"

Sustainability
We operate responsibly every day to improve human and animal health, now and in the future.
Purpose for Progress Impact Report 2024/2025
 Purpose for Progress Report Summary 2024/2025
Purpose for Progress Report Summary 2024/2025
Sustainability is core to how we do business
From expanding access to care to advancing environmental goals, our Purpose for Progress: Merck Impact Report 2024/2025 shows how our company is creating measurable impact — for people, communities and the planet. The name reinforces how our purpose serves as a compass and guides us in our every endeavor. Because progress doesn’t just happen. It’s built — by people, with purpose.
Jump to:
Access to health | Employees | Environmental sustainability | Ethics and values
Watch: Our company’s impact
Our impact by the numbers
People reached with our medicines and vaccines in 2024.
Members of at least one of our 10 employee business resource groups — almost 30% of our workforce globally. All employees are welcome to join any group.
Target date for achieving net-zero greenhouse gas emissions across our global operations (Scopes 1, 2, and 3), aligned with the guidelines of the Science-Based Targets initiative.
Availability of our ethics reporting tool, which allows employees and third parties to raise concerns confidentially and anonymously (where permitted by law).

Access to health
Health breakthroughs matter most when they reach the people who need them. In 2024, we reached 92% of the world’s countries with our products.
Access to health at a glance:
Fact sheet: Our impact by the numbers
Infographic: Expanding access to health

Employees
Our people are at the heart of our purpose. In 2024, our employees dedicated more than 3 million hours to learning — from hands-on training to leadership development. We’re investing in growth, well-being and opportunity so every employee can lead with purpose and shape what’s next.
Employees at a glance:
Fact sheet: Our workforce by the numbers
Infographic: Empowering employees through learning and development

Environmental sustainability
We’re working toward a future where people and the planet can thrive. We’ve committed to sourcing 100% of our purchased electricity from renewable energy by 2025. It’s all part of our journey to net zero.
Environmental sustainability at a glance:
Fact sheet: Our environmental sustainability impact by the numbers
Infographic: Powering health starts with a healthy planet

Ethics and values
We’re guided by values and driven by integrity. In 2024, more than 99% of employees completed ethics training, and we spent $4 billion with small Tier 1 and 2 suppliers globally, fostering a healthy supply chain. It’s how we earn trust, every day, everywhere we work.
Ethics and values at a glance:
Fact sheet: Our commitment to ethics by the numbers
Infographic: Speak up – Powering a culture of integrity

Philanthropy
We provide financial and product donations to help advance health equity, support local communities and address critical social needs. Explore more

Impact Venture Fund
We invest in funds and companies working to improve access to health and, in turn, create financial returns and strategic opportunities for our company. Learn more

Sustainability resources
Our reports, policies, resources and guidelines govern the work we do every day. Learn more

Transparency disclosures
We aspire to be transparent about how we operate to earn the trust and confidence of our customers and other stakeholders. Explore more